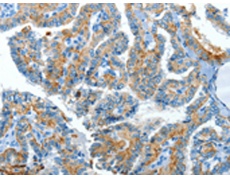
一抗

中文名稱:兔抗CLPTM1L多克隆抗體
|
Background: |
Cleft lip and palate transmembrane protein 1-like protein (CLPTM1-like protein), also known as cisplatin resistance-related protein 9 (CRR9p), is a protein that in humans is encoded by the CLPTM1L gene. CRR9p is associated with cisplatin-induced apoptosis. CLPTM1L, which lies within a cancer susceptibility locus on chromosome 5 (5p15.33), has been found to be commonly over-expressed in lung tumors and to confer resistance to apoptosis caused by genotoxic agents in association with up-regulation of the anti-apoptotic protein, Bcl-xL. |
|
Applications: |
ELISA, IHC |
|
Name of antibody: |
CLPTM1L |
|
Immunogen: |
Synthetic peptide of human CLPTM1L |
|
Full name: |
CLPTM1-like |
|
Synonyms: |
CRR9 |
|
SwissProt: |
Q96KA5 |
|
ELISA Recommended dilution: |
1000-5000 |
|
IHC positive control: |
Human thyroid cancer and Human esophagus cancer |
|
IHC Recommend dilution: |
50-200 |

 購物車
購物車 幫助
幫助
 021-54845833/15800441009
021-54845833/15800441009